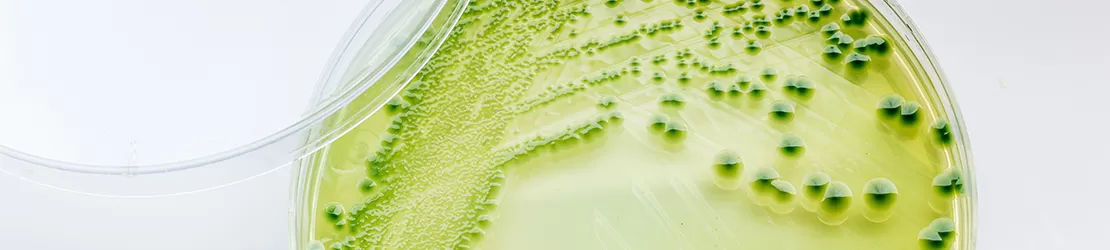
cultura de Vibrio cholerae

Despre holeră
Holera este o boală infecţioasă intestinală acută, contagioasă, care se manifestă prin diaree apoasă, pierdere extremă de lichide și electroliți și deshidratare severă.
În ciuda faptului că este ușor de tratat, se estimează că holera afectează între 3 și 5 milioane de persoane în fiecare an și provoacă peste 100.000 de decese în întreaga lume.
Din cauza deshidratării severe, rata de mortalitate este ridicată atunci când boala nu este tratată, în special în rândul copiilor și sugarilor. Decesul poate surveni în câteva ore la adulții altfel sănătoși, dar cei care se recuperează obţin, de obicei, imunitate pe termen lung.
Această boală nu trebuie confundată cu holera aviară care este cauzată de bacteria Pasteurella multocida, afectează în principal păsările și poate provoca infecții respiratorii și sistemice. Deși cele două boli sunt cauzate de bacterii diferite și afectează specii diferite, ambele sunt denumite „holeră” deoarece au unele simptome comune, cum ar fi diareea severă și deshidratarea. În plus, ambele boli pot fi transmise prin intermediul surselor de apă contaminate și au metode similare de control, cum ar fi îmbunătățirea practicilor de igienă și salubritate și administrarea de antibiotice în cazul focarelor de holeră aviară.
Cauze
Holera este cauzată de bacteria numită Vibrio cholerae (vibrionul holeric), dar efectele mortale ale bolii sunt rezultatul unei toxine pe care bacteria o produce în intestinul subțire. Aceasta determină organismul să secrete cantități enorme de apă, ceea ce duce la diaree și la o pierdere rapidă de lichide și săruri (electroliți).
Este posibil ca bacteria holerei să nu provoace îmbolnăviri la toate persoanele care sunt expuse la ea, dar acestea transmit totuși bacteria prin fecale, care pot contamina rezervele de alimente și apă, principala sursă de infectare cu holeră. Bacteria poate fi găsită în:
- apa de suprafață sau de fântână;
- fructe de mare;
- fructe și legume crude;
- cereale.
Factori de risc
Persoanele cele mai expuse riscului de a se infecta sunt:
- angajaţii din domeniul asistenței medicale și cei care tratează persoane cu holeră;
- lucrătorii umanitari care răspund la focarele de holeră;
- persoanele care călătoresc în zone în care holera poate fi încă transmisă și care nu respectă măsurile de igienă și de siguranță alimentară;
- persoanele cu aclorhidrie, o afecțiune care elimină acidul clorhidric din stomac;
- persoanele cu grupa sanguină O (zero);
- persoanele care au afecțiuni medicale cronice;
- cei care nu au acces la terapia de rehidratare orală și la alte servicii medicale.
Simptome
Doar aproximativ 1 din 20 de infecții sunt grave, iar un procent ridicat de persoane infectate nu prezintă nici un simptom de holeră. Dacă apar manifestări, ele debutează între 12 ore și cinci zile de la expunere şi, de obicei, includ:
- diaree;
- vărsături;
- crampe la nivelul gambelor.
O persoană cu holeră poate pierde rapid lichide, până la 20 de litri pe zi, astfel încât poate apărea deshidratarea severă, caracterizată prin:
- piele flască;
- ochi înfundați în orbite;
- gură uscată;
- scăderea secreției, de exemplu, mai puțină transpirație;
- bătăi rapide ale inimii;
- tensiune arterială scăzută;
- stări de amețeală;
- pierdere rapidă în greutate.
Diagnosticare
Medicul specialist infecţionist poate suspecta că un pacient are holeră dacă acesta prezintă simptome dintre cele enumerate mai sus, mai ales dacă a călătorit recent în zone cu risc de holeră sau condiții sanitare precare sau dacă a consumat de curând crustacee.
Medicul va trimite la laborator o mostră din fecalele pacientului pentru testare dar, dacă se suspectează holeră, acesta trebuie să înceapă tratamentul imediat, chiar înainte de a primi rezultatele.
Tratament
În mod normal, deshidratarea este cea care duce la deces, astfel încât cel mai important pas este administrarea unei soluții de hidratare orală, cunoscută și sub numele de terapie de rehidratare orală. Tratamentul constă în consumul unui volum mare de apă ce conţine un amestec de zahăr și săruri.
Cazurile grave de holeră necesită înlocuirea lichidelor pierdute pe cale intravenoasă. Un adult care cântărește 70 de kilograme va avea nevoie de cel puțin şapte litri de lichid administrat intravenos.
Antibioticele pot scurta durata bolii, dar Organizaţia Mondială a Sănătăţii nu recomandă utilizarea în masă a antibioticelor pentru holeră din cauza riscului tot mai mare de rezistență bacteriană.
Medicamentele antidiareice nu sunt folosite deoarece împiedică eliminarea bacteriilor din organism.
Complicații
Holera poate deveni rapid fatală. În cele mai grave cazuri, pierderea severă a unor cantități mari de lichide și electroliți poate duce la deces în câteva ore. În situații mai puțin extreme, decesul poate surveni din cauza deshidratării și a șocului la câteva ore sau zile după ce simptomele holerei au apărut pentru prima dată.
Deși șocul și deshidratarea severă sunt cele mai grave complicații ale holerei, pot apărea și alte probleme, cum ar fi:
- scăderea nivelului de zahăr din sânge (hipoglicemie);
- niveluri scăzute de potasiu;
- insuficiență renală.
Prevenție
Holera este, adesea, răspândită prin intermediul alimentelor și din cauza igienei precare, iar unele măsuri simple pot reduce riscul de a contracta boala:
- mâncați numai fructe pe care le-ați decojit;
- evitați salatele, peștele crud și legumele nefierte;
- asigurați-vă că alimentele sunt bine gătite;
- asigurați-vă că apa este îmbuteliată sau fiartă și că poate fi consumată în siguranță;
- evitați mâncarea de tip “street food”, deoarece aceasta poate fi purtătoare de bacterii ce cauzează holeră și alte boli.
Călătorii ar trebui să se informeze despre riscurile și incidența holerei înainte de a vizita o țară în care această boală este răspândită.
Autor
Bibliografie
- Kraft, Sy. “Cholera: Causes, Symptoms, and Treatment.” Www.medicalnewstoday.com, 11 Jan. 2018, www.medicalnewstoday.com
- Mayo Clinic. “Cholera - Symptoms and Causes.” Mayo Clinic, 26 Feb. 2022, www.mayoclinic.org
- NHS Choices. “Cholera.” NHS, 2019, www.nhs.uk
Echipa medicală - Boli infectioase
Solicită o programare
Alege opțiunea de a te programa online, simplu și rapid, prin intermediul formularului de programare.